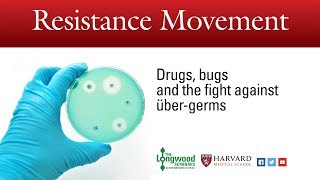
Resistance Movement: Drugs, bugs and the fight against über-germs - Longwood Seminar

Song info
"Organism"
(2006)
on the album Wastrels and Whippersnappers(2006).
0 người yêu thích
"Organism" Videos
Lyrics
Oh! We don't have the lyrics to this song yet.
- 0 Bản dịch
Albums has song "Organism"

Wastrels and Whippersnappers
2006 22 songs
- Intro/Sweet and Sour, Pt. 2 2006
- Dresden Style 2006
- Pets' Corner 2006
- Shubunkin 2006
- Sahara 2006
- Organism 2006
- Full Moon-Blam-Full Moon 2006
- Instronaut 2006
- Televisions 2006
- Wireless 2006
- Harmony in Your Bathroom 2006
- Camoflage Attack 2006
- Gramofonica 2006
- Harvist 2006
- Johnny Seven 2006
- Sweet and Sour (Parts 2, 3 & 4) 2006
- Sheep Police/Septipede 2006
- Improv Number One 2006
- Platinum Blind 2006
- God Save the Queen 2006
- Ratbag and Goblin ('Batman' Theme) 2006
- Vertical Slumber 2006

Recent comments